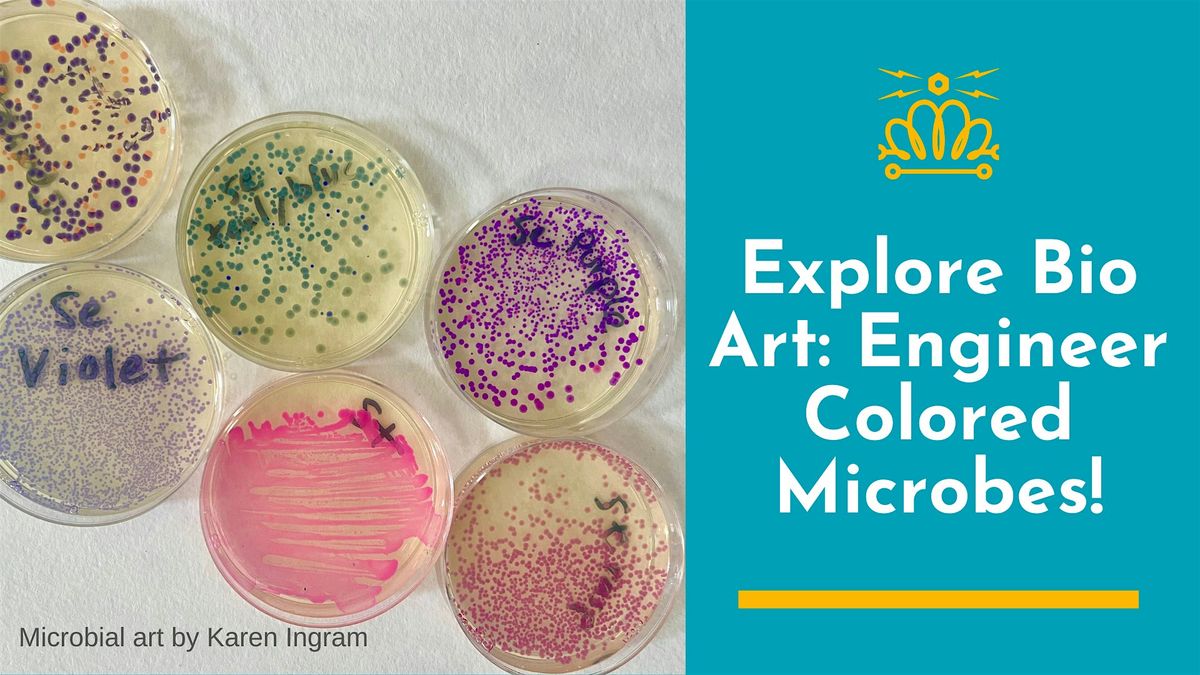

Explore Bio Art: Engineer Colored Microbes!
Schedule
Mon Mar 16 2026 at 06:00 pm to 08:00 pm
UTC-04:00Location
1003 Louise Ave | Charlotte, NC
About this Event
LOCATION:
MakerSpace Charlotte
1003 Louise Ave. Suite A
Charlotte. NC 28205
This is a two-session class. Attendees should expect to be present for both sessions to get the full experience. Please note the dates:
Session 1: Monday, March 16, 6:00–8:00 PM
Session 2: Tuesday, March 17, 6:00–8:00 PM
Registration includes both sessions.
Use a simple bacterial transformation protocol to engineer K12 E.coli to produce a rainbow of 10 vibrant colors; Magenta, yellow, cyan (GFP), raspberry red (RFP), violet, teal, orange, blue, purple, and pearly grey.
The bacterial transformation process will allow you to insert a small loop of DNA called a plasmid into the bacteria in order for it to produce one of these rainbow colors. Each attendee will engineer a color of the rainbow from a plasmid.
Attendees can view their plates incubating remotely online via an imaging system.
They will not be able to take microbes home.
In this workshop, you will:
- Learn about the transformation process and different types of gene editing
- Use sterile technique to work with microbes
- Perform a simple bacterial transformation: engineer E.coli to generate color of the rainbow with a plasmid
- Learn basic microbiology techniques like streaking, colony picking, etc
- Paint an image of your choosing using gene edited microbes
The microbes we are using are non-pathogenic strains of K12 E.coli used for the purpose of education. Recommended: take prior to this class for familiarity with microbes. We will engineer the microbes to display vibrant colors from sea creatures like jellyfish, sea anemone, and coral. These microbes are classified as BSL-1 (bio safety level 1), which means they do not cause disease in humans. BSL-1 microorganisms are used for safe teaching in schools at the high school and university level.
There will be more classes scheduled in the future!

**Participants should wear closed-toe shoes and pull back long hair. No food or drinks will be permitted while we are working with the microbes.
This class is open to ages 10 and up. Children below the age of 16 must be accompanied by a parent who also has a ticket. For questions about this class, please email [email protected]

About your instructor:
Karen Ingram is an artist, designer, and educator working at the intersection of biotechnology and art for over a decade. Her floral paintings made with genetically modified microbes on Petri dishes have been featured in Nature Biotechnology. She's co-author of "BioBuilder: Synthetic Biology in the Lab" (O'Reilly, 2015), was an Emerging Tech fellow at Stanford's d.school, taught at Genspace (Brooklyn's community biotech lab), and is a member of Biotech Without Borders in Queens, NY. Her work has been exhibited at BioBAT Art Space, London Design Week, and Times Square.
Refund Policy:
Transfers to another class follow the same refund rules as your original date. 14+ days before the first class: Full refund. 7–13 days before the first class: Refund minus a 50% administrative fee. Fewer than 7 days before the first class: No refunds.
Seat transfer: If you find a replacement who pays for and takes your seat before the first class begins, you are eligible for a full refund. To cancel or request a transfer, please email [email protected]. For general questions, you’re welcome to visit MakerSpaceCharlotte on Wednesdays at 6:30 PM. For urgent, time-sensitive issues with your reservation, contact Steve at (704) 353-3300.
Cancellation Policy: Class may be canceled due to low enrollment, in which case a full refund will be issued. MakerSpace reserves the right to cancel any class with insufficient enrollment. If a class is canceled by MakerSpace, fees are 100% refundable.

Where is it happening?
1003 Louise Ave, 1003 Louise Avenue, Charlotte, United StatesEvent Location & Nearby Stays:
USD 230.87




















